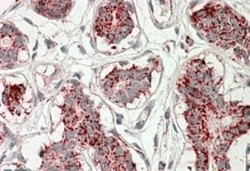

Antibody data
- Antibody Data
- Antigen structure
- References [1]
- Comments [0]
- Validations
- Western blot [3]
- Immunohistochemistry [1]
Submit
Validation data
Reference
Comment
Report error
- Product number
- NBP1-52015 - Provider product page

- Provider
- Novus Biologicals
- Proper citation
- Novus Cat#NBP1-52015, RRID:AB_11030849
- Product name
- Goat Polyclonal Aconitase 2 Antibody
- Antibody type
- Polyclonal
- Description
- Immunogen affinity purified.
- Reactivity
- Human, Mouse, Rat, Porcine
- Host
- Goat
- Antigen sequence
C-QDTYQHPPKDSSGQH- Isotype
- IgG
- Vial size
- 0.1 mg
- Concentration
- 0.5 mg/ml
- Storage
- Store at -20C. Avoid freeze-thaw cycles.
Submitted references Lon protease preferentially degrades oxidized mitochondrial aconitase by an ATP-stimulated mechanism.
Bota DA, Davies KJ
Nature cell biology 2002 Sep;4(9):674-80
Nature cell biology 2002 Sep;4(9):674-80
No comments: Submit comment
Supportive validation
- Submitted by
- Novus Biologicals (provider)
- Main image

- Experimental details
- Western Blot: Aconitase 2 Antibody [NBP1-52015] - Analysis of Aconitase 2 (aa541-555) in Heart lysate (35ug protein in RIPA buffer) using this antibody at 0.01ug/ml. Primary incubation was 1 hour. Detected by chemiluminescence.
- Submitted by
- Novus Biologicals (provider)
- Main image

- Experimental details
- Western Blot: Aconitase 2 Antibody [NBP1-52015] - Analysis of Mouse (A), Rat (B) and Pig (C) Skeletal Muscle lysates (35 ug protein in RIPA buffer). Primary incubation was 1 hour. Detected by chemiluminescence.
- Submitted by
- Novus Biologicals (provider)
- Main image

- Experimental details
- Western Blot: Aconitase 2 Antibody [NBP1-52015] - Analysis of Human (A), Mouse (B) and Rat (C) Adipose lysates (35 ug protein in RIPA buffer). Primary incubation was 1 hour. Detected by chemiluminescence.
Supportive validation
- Submitted by
- Novus Biologicals (provider)
- Main image
- Experimental details
- Immunohistochemistry-Paraffin: Aconitase 2 Antibody [NBP1-52015] - (3.8ug/ml) staining of paraffin embedded Human Breast. Steamed antigen retrieval with citrate buffer pH 6, AP-staining.